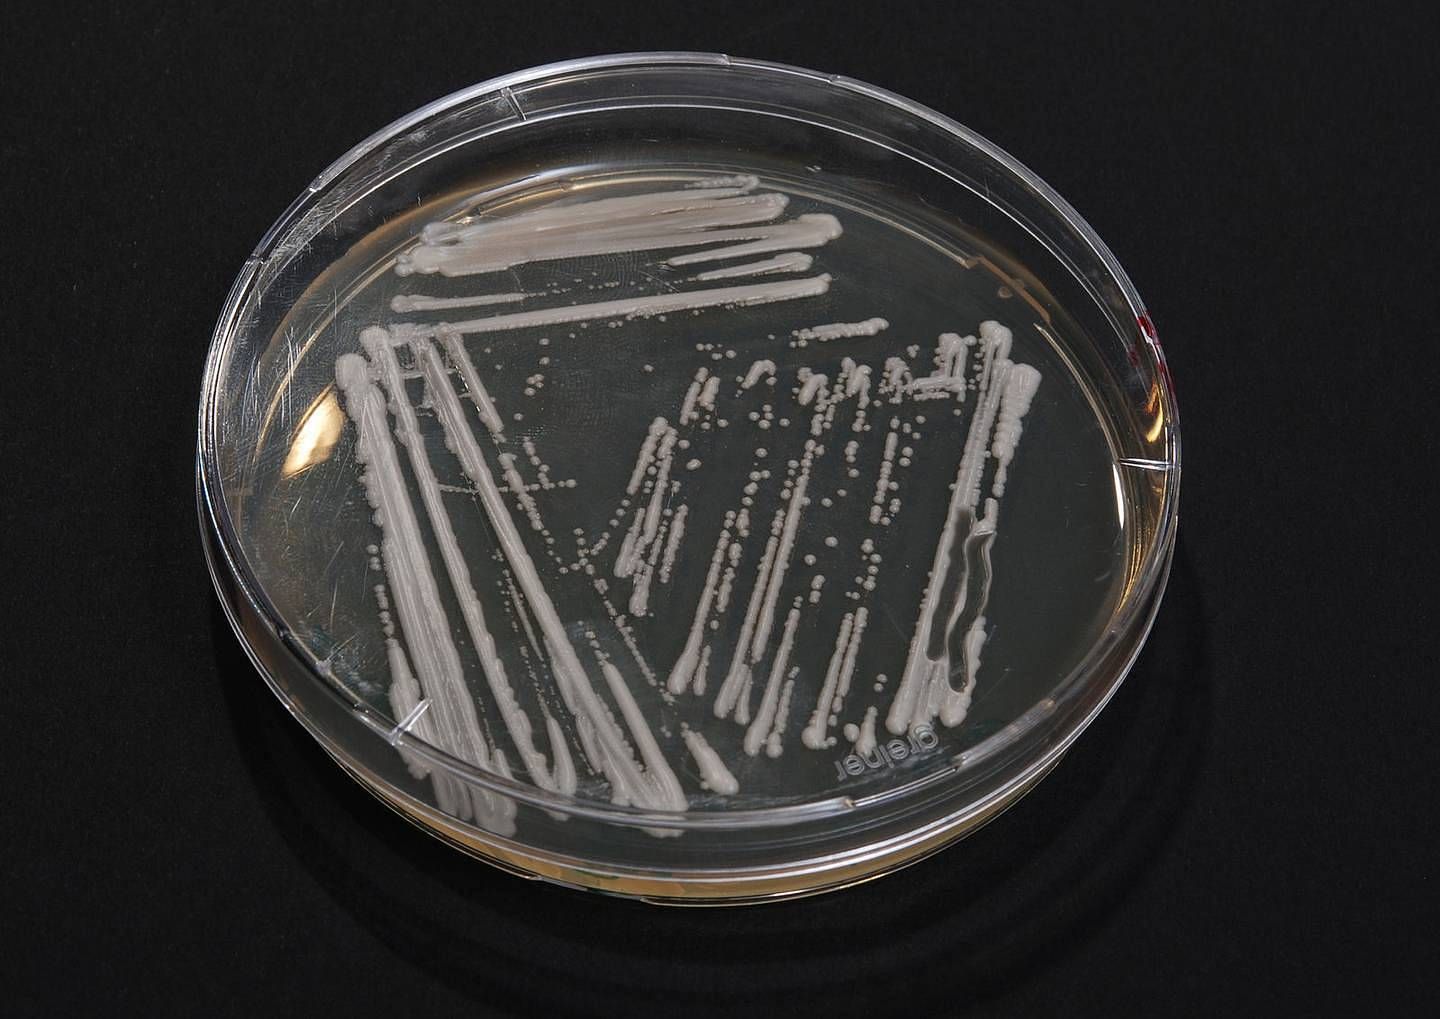

Forscher finden Palmöl-Ersatz
Vielleicht die Rettung für die Orang-Utans?
Beitrag von Anne
10.12.2015
Forscher entwickeln derzeit einen Palmöl-Ersatz auf Hefebasis. Bedeutet das die Rettung der Orang-Utans?
Dass durch die Gewinnung von Palmöl Urwälder abgeholzt werden, ist bekannt. Vor Kurzem erst habe ich über das traurige Schicksal der Orang-Utans, die durch die Brandrodung ihrer Lebensräume kurz vor dem Aussterben stehen, berichtet.
Jetzt ist vielleicht Rettung in Sicht. Forscher und Entwickler von der Universität Bath und der Universität York entwickeln derzeit einen Palmöl-Ersatz auf Hefe-Basis. Diese Alternative könnte das Potential haben, Palmöl komplett den Rang abzulaufen. Das rücksichtslose Abholzen der Regenwälder wäre somit beendet.
Das Leid der Orang-Utans könnte schon bald ein Ende haben
In einem Bericht des HeraldScotland[^1] erklärt Dr. Tim May, der Leiter der chemischen Entwicklungsabteilung an der Universität Bath:
"Unsere Arbeit wird einen signifikanten, positiven Einfluss auf die nachhaltigen Energien sowie die Entwicklung und Herstellung von Nahrungsmitteln und Pflegeprodukten haben."
Weiterhin auf die Inhaltsangaben achten
Auch, wenn diese zukunftsweisende Palmöl-Alternative derzeit noch nicht auf dem Markt ist, handelt es sich dabei um einen Lichtblick. Es ist ein Zeichen an die Industrie, dass es höchste Zeit ist, neue Wege zu gehen. Das Überleben der Orang-Utans ist in der Schwebe, diese willkommene Änderung könnte wirklich etwas für sie bewirken.
Bis es soweit ist, dass der Palmöl-Ersatz auf den Markt kommt und das Palmöl als Zutat in unseren Lebensmitteln, Reinigungs- und Pflegeprodukten ablöst, ist es wichtig, so genau wie möglich auf die Inhaltsangaben zu achten und den Konsum von Produkten mit Palmöl so gut es geht zu vermeiden.
Bild: Creative Commons



